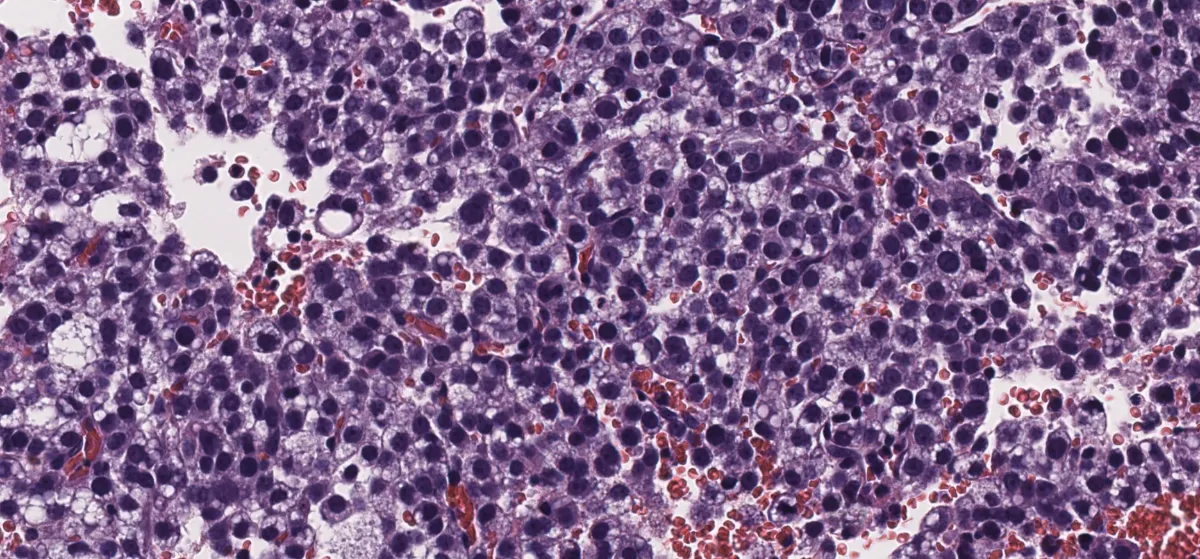

Enhorabuena a Josselyn Andrea Hernández Chinchilla, residente de cuarto año del Hospital Universitario la Fe de Valencia, por ser la autora de nuestro CASO DEL MES CORRELACIÓN CITO-HISTO de JULIO 2025.
DESCRIPCIÓN DEL CASO:
Paciente femenina de 15 años sin antecedentes. Presenta una masa en región cigomática derecha de 3 cm, firme, no dolorosa, sin signos inflamatorios, aparecida en el contexto de un tratamiento de ortodoncia. La resonancia magnética sugiere una lesión inflamatoria, pero tras tratamiento antibiótico sin mejoría, se realiza PAAF intraoral. La citología muestra células atípicas con características lipoblastoides, abundante fondo mixoide y vascularización capilar plexiforme. Se observan mitosis atípicas y positividad para Vimentina y Adipofilina. No se detectan translocaciones de DDIT3 ni PLAG1, ni amplificación de MDM2.
En la biopsia se observa una lesión multinodular, no encapsulada, con estroma mixoide y vasos en patrón plexiforme. Se identifican células pleomórficas, algunas multinucleadas, con citoplasma microvacuolado, dispuestas en patrón laxo. La inmunohistoquímica muestra positividad para S-100 (heterogénea), p16 (intensa), SOX9, andrógenos y SF-1, con un Ki67 del 25%. Mitosis ocasionalmente atípicas. Negatividad para múltiples marcadores epiteliales, musculares y neuroendocrinos.
Imágenes:

Diff-Quik Cito 1

Diff-Quik Cito 2

Diff-Quik Cito 3

Diff-Quik Cito 4

Diff-Quik Cito 5

Diff-Quik Cito 6

papanicolau-ciito (1)

papanicolau-ciito (2)

HE – biopsia (1)

HE – biopsia (2)

HE – biopsia (3)

HE – biopsia (4)
HE – biopsia (5)

HE – biopsia (6)

HE – biopsia (8)

ki67-biopsia

MDM2 – biopsia

s100 – biopsia
¿Cuál es tu diagnóstico?
El diagnóstico y los aspectos esenciales de esta entidad se encuentran a continuación…
Diagnóstico: liposarcoma mixoide pleomórfico de región cigomática.
Aspectos esenciales:
- El liposarcoma mixoide pleomórfico (LMP) es una variante recientemente reconocida en la clasificación OMS 2020, con comportamiento clínico agresivo. PMID: 38929567
- Afecta predominantemente a adultos jóvenes, aunque puede presentarse en edades avanzadas. Su localización más frecuente es retroperitoneal, siendo excepcional en cabeza y cuello. PMID: 38929567
- Histológicamente, combina áreas de liposarcoma mixoide con pleomorfismo celular prominente. No presenta reordenamientos típicos de DDIT3, a diferencia del liposarcoma mixoide clásico. (PMID: 15920549
- La inmunohistoquímica suele ser negativa para MDM2 y CDK4, ayudando en el diagnóstico diferencial con liposarcoma desdiferenciado y otras neoplasias de partes blandas. PMID: 15920549
- El tratamiento de elección es la resección quirúrgica amplia. La evidencia sobre el beneficio de radioterapia o quimioterapia es limitada, dada la rareza del tumor. PMID: 35672466
- El pronóstico es reservado, con alta tasa de recurrencia y metástasis, principalmente pulmonares. Requiere seguimiento estrecho por su comportamiento impredecible. PMID: 35672466

